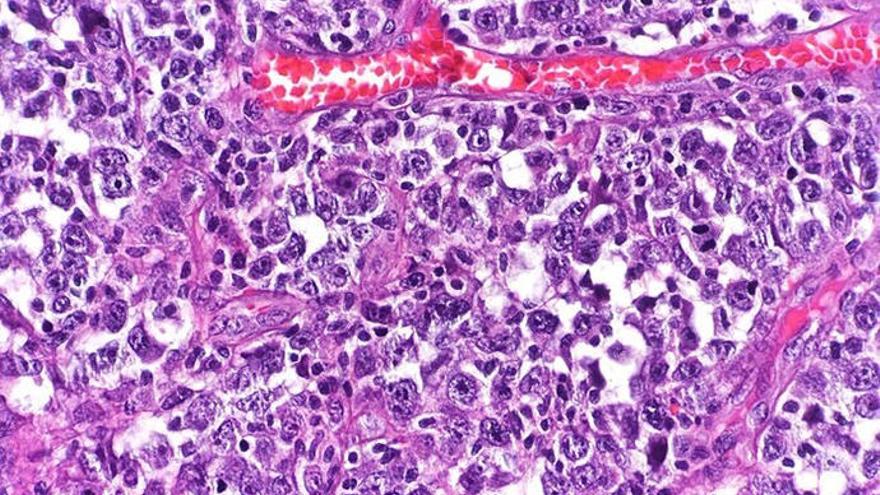

El primer ensayo con un medicamento de inmunoterapia CAR-T producido íntegramente en el Hospital de Sant Pau de Barcelona para el tratamiento de linfoma ha dado buenos resultados en la primera fase, con una elevada efectividad para eliminar el cáncer ya que se logró en la mitad de los 10 pacientes participantes.
Los linfomas son un tipo de cáncer en la sangre que comienza en las células del sistema linfático y para los que resulta efectivo el tratamiento con CAR-T.
Se trata de una terapia avanzada que consiste en alterar las células T del propio cuerpo (un tipo de glóbulos blancos claves en el sistema inmunitario) para que puedan encontrar y destruir las células cancerosas.
"Seleccionamos estos linfocitos T del mismo paciente y los dotamos de un 'arma' para que, cada vez que detecte uno de los antígenos CD30 -los que expresan las células tumorales del linfoma -, las elimine", ha detallado el responsable clínico del proyecto de CAR-T de Sant Pau, Javier Briones.
Así, de esta forma permanece en el cuerpo del paciente un "detector y eliminador" de cualquier célula del linfoma que volviera a aparecer.
"En definitiva, es la modificación genética de los linfocitos T del mismo paciente para que éstos ataquen células cancerosas", ha añadido.
Diversos hospitales aplican ya terapias CAR-T que, mayoritariamente, son adaptaciones a partir de productos de la industria farmacéutica, pero en el caso de Sant Pau el tratamiento se ha producido de principio a fin en el mismo centro.
En la fase I del ensayo, aprobado por la Agencia Española de Medicamentos y Productos Sanitarios (AEMPS), han participado 10 pacientes con linfoma de Hodgkin y linfoma T, refractarios a todos los tratamientos convencionales aprobados.
Las células T de memoria CAR30 (HSP-CAR30), que se han modificado y reintroducido en el paciente para el tratamiento de inmunoterapia, han demostrado tener "un excelente perfil de seguridad" y los datos preliminares del estudio muestran además "una altísima eficacia", ya que un 50 % de los pacientes tuvieron una respuesta completa al tratamiento con desaparición del linfoma, según Sant Pau.
Tras estos resultados, el ensayo prosigue en la fase II y los pacientes seleccionados ya han comenzado a recibir el tratamiento en el hospital decano de Barcelona.
Desde que en 2020 el Instituto de Investigación IIB Sant Pau, en colaboración con el Banco de Sangre y Tejidos de Cataluña, obtuviera el certificado de la AEMPS para la producción y control de calidad de medicamentos celulares tipo CAR-T, varios organismos y fundaciones han apoyado este proyecto de Sant Pau.
El Instituto de Investigación contra la Leucemia Josep Carreras ha colaborado en el proyecto con la adquisición de una parte importante del equipamiento y la provisión de fondos para la producción de fármacos para los 10 primeros pacientes.
Otros organismos como el Instituto de Salud Carlos III, la Fundación "La Caixa" y la Asociación Española Contra el Cáncer (AECC) también han apoyado el desarrollo de este proyecto de investigación.